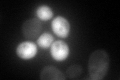
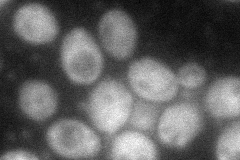
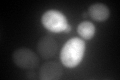

View description
Dihydroorotate dehydrogenase, catalyzes the fourth enzymatic step in the de novo biosynthesis of pyrimidines, converting dihydroorotic acid into orotic acid
Localization:
Intensity:
Fold change:
Significance:
-
C’ GFP library in SD
cytosol91.59 -
N' NOP1pr-GFP in SD

cytosol191.402 -
N' TEF2pr-mCherry in SD

cytosol26.1251 -
N' NATIVEpr-GFP in SD

cytosol357.779 -
N' TEF2pr-VC and Cyto-VN in SD
cytosol65.5563 -
C’ GFP library in SD+DTT
cytosol39.460.43Yes -
C’ GFP library in SD+H2O2

cytosol50.90.55Yes -
C’ GFP library in Starvation Media

cytosol26.430.28No -
C’ GFP library on the background of Pup2-DaMP

cytosol -
C’ GFP library on the background of CCT mutant

cytosol221.242.41532Yes
